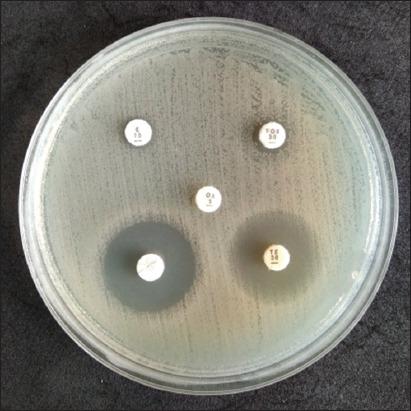
https://cdn.ncbi.nlm.nih.gov/pmc/blobs/1869/10884576/5a28e99482ec/Vetworld-17-216-g002.jpg

印度尼西亚勿里达市牛奶中分离出的耐甲氧西林基因亲缘关系分析及奶农的风险因素分析
Kinship analysis of gene of methicillin-resistant isolated from milk and risk factors from the farmers in Blitar, Indonesia.
作者信息
Khairullah Aswin Rafif, Kurniawan Shendy Canadya, Sudjarwo Sri Agus, Effendi Mustofa Helmi, Widodo Agus, Moses Ikechukwu Benjamin, Hasib Abdullah, Zahra Reichan Lisa Az, Gelolodo Maria Aega, Kurniawati Dyah Ayu, Riwu Katty Hendriana Priscilia, Silaen Otto Sahat Martua, Afnani Daniah Ashri, Ramandinianto Sancaka Cashyer
机构信息
Division of Animal Husbandry, Faculty of Veterinary Medicine, Universitas Airlangga, Jl. Dr. Ir. H. Soekarno, Kampus C Mulyorejo, Surabaya 60115, East Java, Indonesia.
Master Program of Animal Sciences, Department of Animal Sciences, Specialisation in Molecule, Cell and Organ Functioning, Wageningen University and Research, Wageningen 6708 PB, Netherlands.
出版信息
Vet World. 2024 Jan;17(1):216-225. doi: 10.14202/vetworld.2024.216-225. Epub 2024 Jan 25.
BACKGROUND AND AIM
There are numerous reports of subclinical mastitis cases in Blitar, which is consistent with the region's high milk production and dairy cattle population. , which is often the cause of mastitis cases, is widely known because of its multidrug-resistant properties and resistance to β-lactam antibiotic class, especially the methicillin-resistant (MRSA) strains. This study aimed to molecular detection and sequence analysis of the gene in milk and farmer's hand swabs to show that dairy cattle are reservoirs of MRSA strains.
MATERIALS AND METHODS
A total of 113 milk samples and 39 farmers' hand swab samples were collected from a dairy farm for the isolation of using Mannitol salt agar. The recovered isolates were further characterized using standard microbiological techniques. Isolates confirmed as were tested for sensitivity to antibiotics. Oxacillin Resistance Screening Agar Base testing was used to confirm the presence of MRSA, whereas the gene was detected by polymerase chain reaction and sequencing.
RESULTS
A total of 101 samples were confirmed to be . There were 2 isolates that were multidrug-resistant and 14 isolates that were MRSA. The gene was detected in 4/14 (28.6%) phenotypically identified MRSA isolates. Kinship analysis showed identical results between from milk and farmers' hand swabs. No visible nucleotide variation was observed in the two sequences of isolates from Blitar, East Java.
CONCLUSION
The spread of MRSA is a serious problem because the risk of zoonotic transmission can occur not only to people who are close to livestock in the workplace, such as dairy farm workers but also to the wider community through the food chain.
背景与目的
在勿里达有大量亚临床乳腺炎病例的报告,这与该地区较高的牛奶产量和奶牛数量相符。由于其多重耐药特性以及对β-内酰胺类抗生素尤其是耐甲氧西林金黄色葡萄球菌(MRSA)菌株的耐药性,金黄色葡萄球菌(常为乳腺炎病例的病因)广为人知。本研究旨在对牛奶和农民手部拭子中的金黄色葡萄球菌基因进行分子检测和序列分析,以表明奶牛是MRSA菌株的储存宿主。
材料与方法
从一个奶牛场收集了总共113份牛奶样本和39份农民手部拭子样本,用于使用甘露醇盐琼脂分离金黄色葡萄球菌。使用标准微生物技术对回收的分离株进行进一步鉴定。对确认为金黄色葡萄球菌的分离株进行抗生素敏感性测试。使用苯唑西林耐药筛选琼脂基础测试来确认MRSA的存在,而通过聚合酶链反应和测序检测mecA基因。
结果
总共101份样本被确认为金黄色葡萄球菌。有2株金黄色葡萄球菌分离株具有多重耐药性,14株为MRSA。在4/14(28.6%)表型鉴定为MRSA的分离株中检测到mecA基因。亲缘关系分析显示牛奶和农民手部拭子中的金黄色葡萄球菌结果相同。在东爪哇勿里达分离株的两个mecA序列中未观察到明显的核苷酸变异。
结论
MRSA的传播是一个严重问题,因为人畜共患病传播的风险不仅可能发生在工作场所接近牲畜的人群中,如奶牛场工人,还可能通过食物链传播给更广泛的社区。